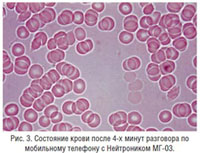

METOD FUNKCIONALNOG HEMOSKENIRANJA KRVI
Funkcionalno hemoskeniranje je metod dijagnostike “žive” kapi krvi koji omogućuje da se odredi funkcionalno stanje elemenata krvi i plazme u svetlom ili tamnom polju. Pri sprovođenju ispitivanja u tamnom polju koriste se specijalni tamnopoljni mikroskopi (Dark-field microscopy) povezani sa kamerama ili kompjuterima.
Pri klasičnim kliničkim analizama krvi, krv iz palca ili vene nanosi se na staklenu pločicu, suši se, zatim se boji hematoksilin-eozinom, posle čega se vrši ispitivanje. Ovo je jednostavan, širokorasprostranjen metod kojim se analiziraju fiksirane (mrtve) ćelije krvi.
Funkcionalno hemoskeniranje izvodi se u prisustvu pacijenta, a stanje krvi se vidi u realnom vremenu na ekranu kompjutera. Ova metoda omogućuje određivanje:
-
- Funkcijskog stanja eritrocita i trombocita
- Stanja imunog sistema (prisustvo pokazatelja imunodeficita)
- Prisustva bakterija, protozoa, gljivica, larvi glista i unutarćelijskih parazita
- Prisustva narušenog metabolizma
- Dehidracije organizma
- Stepena sniženja pH vrednosti krvi
- Pravilnosti sprovedene terapije
Krv je informaciona struktura. Zahvaljujući ovom metodu analize „žive“ kapi krvi može se oceniti stanje celog organizma u datom trenuktu, postojeći preduslovi za razvoj bolesti, kao i uzroke već prisutne bolesti.
Ispitivanje efikasnosti NEITRONIKA metodom funkcionalnog hemoskeniranja
Vršeno je ispitivanje stanja eritrocita u krvi zdravog čoveka pre i za vreme upotrebe mobilnog telefona bez i sa zaštitnim sredstvom NEITRONIK MG-03. Dužina razgovora mobilnim telefonom bila je 4 minuta. Na slikama 1, 2 i 3 prikazana dinamika promene stanja krvi (eritrocita) čoveka u trima fazama ispitivanja. Na slici 1. prikazani su eritrociti zdravog čoveka pre početka testiranja. Na slici 2. se vidi da pod dejstvom elektromagnetnog zračenja mobilnog telefona dolazi do agregacije (slepljivanja) eritrocita. Kako je poznato agregacija eritrocita dovodi do anemije, otežane kapilarne cirkulacije, poremećaja u metabolizmu, poremećeja u radu imunog sistema i mozga, pogoršanja energetskog stanja organizma. Na slici 3. je prikazano stanje eritrocita posle četvorominutnog razgovora mobilnim telefonom sa nalepljenim NEITRONIKOM MG-03. Uočljiva je znatno manja agregacija eritrocita bliska kontrolnom stanju.